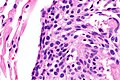

Difference between revisions of "Pulmonary carcinoid tumourlet"
Jump to navigation
Jump to search
| (10 intermediate revisions by the same user not shown) | |||
| Line 1: | Line 1: | ||
{{ Infobox diagnosis | {{ Infobox diagnosis | ||
| Name = {{PAGENAME}} | | Name = {{PAGENAME}} | ||
| Image = | | Image = Lung carcinoid tumourlet - low mag.jpg | ||
| Width = | | Width = | ||
| Caption = | | Caption = Lung carcinoid tumourlet. [[H&E stain]]. | ||
| Synonyms = carcinoid tumourlet | | Synonyms = carcinoid tumourlet | ||
| Micro = cells with salt and pepper chromatin, usually nested architecture, no necrosis, minimal mitotic activity (see below) | | Micro = cells with salt and pepper chromatin, usually nested architecture, no necrosis, minimal mitotic activity (see below), must be through the bronchial basement membrane | ||
| Subtypes = | | Subtypes = | ||
| LMDDx = [[typical carcinoid lung tumour]], [[atypical lung carcinoid tumour]] | | LMDDx = [[pulmonary neuroendocrine cell hyperplasia]], [[typical carcinoid lung tumour]], [[atypical lung carcinoid tumour]], [[pulmonary meningothelial-like nodule]] | ||
| Stains = | | Stains = | ||
| IHC = Ki-67 ~2% (0-7%) | | IHC = Ki-67 ~2% (0-7%) | ||
| Line 17: | Line 17: | ||
| Site = [[lung]] - see ''[[lung tumours]]'' | | Site = [[lung]] - see ''[[lung tumours]]'' | ||
| Assdx = | | Assdx = | ||
| Syndromes = | | Syndromes = [[Diffuse idiopathic pulmonary neuroendocrine cell hyperplasia]] | ||
| Clinicalhx = often an incidental finding | | Clinicalhx = often an incidental finding | ||
| Signs = | | Signs = | ||
| Line 42: | Line 42: | ||
==Microscopic== | ==Microscopic== | ||
Features: | Features: | ||
* | *Neuroendocrine cells - usually in nests (classic pattern). | ||
**Salt and pepper chromatin - '''key feature'''. | **Salt and pepper chromatin - '''key feature'''. | ||
*Nuclei round or ellipsoid. | |||
*Size criterion: <5 mm.<ref name=pct_ucsf>URL: [http://pathhsw5m54.ucsf.edu/case7/image75.html http://pathhsw5m54.ucsf.edu/case7/image75.html]. Accessed on: 23 January 2012.</ref><ref name=pmid23205296>{{Cite journal | last1 = He | first1 = P. | last2 = Gu | first2 = X. | last3 = Wu | first3 = Q. | last4 = Lin | first4 = Y. | last5 = Gu | first5 = Y. | last6 = He | first6 = J. | title = Pulmonary carcinoid tumorlet without underlying lung disease: analysis of its relationship to fibrosis. | journal = J Thorac Dis | volume = 4 | issue = 6 | pages = 655-8 | month = Dec | year = 2012 | doi = 10.3978/j.issn.2072-1439.2012.06.11 | PMID = 23205296 }}</ref> | *Size criterion: <5 mm.<ref name=pct_ucsf>URL: [http://pathhsw5m54.ucsf.edu/case7/image75.html http://pathhsw5m54.ucsf.edu/case7/image75.html]. Accessed on: 23 January 2012.</ref><ref name=pmid23205296>{{Cite journal | last1 = He | first1 = P. | last2 = Gu | first2 = X. | last3 = Wu | first3 = Q. | last4 = Lin | first4 = Y. | last5 = Gu | first5 = Y. | last6 = He | first6 = J. | title = Pulmonary carcinoid tumorlet without underlying lung disease: analysis of its relationship to fibrosis. | journal = J Thorac Dis | volume = 4 | issue = 6 | pages = 655-8 | month = Dec | year = 2012 | doi = 10.3978/j.issn.2072-1439.2012.06.11 | PMID = 23205296 }}</ref> | ||
*Must be through the bronchial basement membrane.<ref name=pmid20729444>{{Cite journal | last1 = Koo | first1 = CW. | last2 = Baliff | first2 = JP. | last3 = Torigian | first3 = DA. | last4 = Litzky | first4 = LA. | last5 = Gefter | first5 = WB. | last6 = Akers | first6 = SR. | title = Spectrum of pulmonary neuroendocrine cell proliferation: diffuse idiopathic pulmonary neuroendocrine cell hyperplasia, tumorlet, and carcinoids. | journal = AJR Am J Roentgenol | volume = 195 | issue = 3 | pages = 661-8 | month = Sep | year = 2010 | doi = 10.2214/AJR.09.3811 | PMID = 20729444 }}</ref> | |||
DDx: | DDx: | ||
*Pulmonary neuroendocrine cell hyperplasia - proliferation confined by bronchial basement membrane.<ref name=pmid20729444>{{Cite journal | last1 = Koo | first1 = CW. | last2 = Baliff | first2 = JP. | last3 = Torigian | first3 = DA. | last4 = Litzky | first4 = LA. | last5 = Gefter | first5 = WB. | last6 = Akers | first6 = SR. | title = Spectrum of pulmonary neuroendocrine cell proliferation: diffuse idiopathic pulmonary neuroendocrine cell hyperplasia, tumorlet, and carcinoids. | journal = AJR Am J Roentgenol | volume = 195 | issue = 3 | pages = 661-8 | month = Sep | year = 2010 | doi = 10.2214/AJR.09.3811 | PMID = 20729444 }}</ref> | *[[Pulmonary neuroendocrine cell hyperplasia]] - proliferation confined by bronchial basement membrane.<ref name=pmid20729444>{{Cite journal | last1 = Koo | first1 = CW. | last2 = Baliff | first2 = JP. | last3 = Torigian | first3 = DA. | last4 = Litzky | first4 = LA. | last5 = Gefter | first5 = WB. | last6 = Akers | first6 = SR. | title = Spectrum of pulmonary neuroendocrine cell proliferation: diffuse idiopathic pulmonary neuroendocrine cell hyperplasia, tumorlet, and carcinoids. | journal = AJR Am J Roentgenol | volume = 195 | issue = 3 | pages = 661-8 | month = Sep | year = 2010 | doi = 10.2214/AJR.09.3811 | PMID = 20729444 }}</ref> | ||
*[[Typical carcinoid lung tumour]] - must be >= 5 mm. | *[[Typical carcinoid lung tumour]] - must be >= 5 mm. | ||
*[[Pulmonary meningothelial-like nodule]] - whorled appearance, ''not'' associated with an airway. | |||
===Images=== | ===Images=== | ||
<gallery> | |||
Image: Lung carcinoid tumourlet - very low mag.jpg | CT - very low mag. (WC) | |||
Image: Lung carcinoid tumourlet - low mag.jpg | CT - low mag. (WC) | |||
Image: Lung carcinoid tumourlet - intermed mag.jpg | CT - intermed. mag. (WC) | |||
Image: Lung carcinoid tumourlet - high mag.jpg | CT - high mag. (WC) | |||
Image: Lung carcinoid tumourlet - alt - high mag.jpg | CT - high mag. (WC) | |||
Image: Lung carcinoid tumourlet - very high mag.jpg | CT - very high mag. (WC) | |||
Image: Lung carcinoid tumourlet - alt - very high mag.jpg | CT - very high mag. (WC) | |||
</gallery> | |||
www: | |||
*[http://pathhsw5m54.ucsf.edu/case7/image75.html Tumourlets - several images (ucsf.edu)]. | *[http://pathhsw5m54.ucsf.edu/case7/image75.html Tumourlets - several images (ucsf.edu)]. | ||
Latest revision as of 03:30, 22 March 2018
| Pulmonary carcinoid tumourlet | |
|---|---|
| Diagnosis in short | |
 Lung carcinoid tumourlet. H&E stain. | |
|
| |
| Synonyms | carcinoid tumourlet |
|
| |
| LM | cells with salt and pepper chromatin, usually nested architecture, no necrosis, minimal mitotic activity (see below), must be through the bronchial basement membrane |
| LM DDx | pulmonary neuroendocrine cell hyperplasia, typical carcinoid lung tumour, atypical lung carcinoid tumour, pulmonary meningothelial-like nodule |
| IHC | Ki-67 ~2% (0-7%) |
| Gross | <5 mm by definition |
| Site | lung - see lung tumours |
|
| |
| Syndromes | Diffuse idiopathic pulmonary neuroendocrine cell hyperplasia |
|
| |
| Clinical history | often an incidental finding |
| Prevalence | not common |
| Prognosis | benign |
Pulmonary carcinoid tumourlet, also carcinoid tumourlet, is a small benign proliferation of Kulchitsky cells.
The entity is separated from the typical lung carcinoid tumour by size. Carcinoid tumourlets are < 5 mm, typical lung carcinoid tumours are >=5 mm.
General
- Neuroendocrine cell proliferation.[1]
- Essentially a small typical carcinoid.
- Arise from Kulchitsky cells of the bronchial epithelium.[2]
- May be seen in the context of diffuse idiopathic pulmonary neuroendocrine cell hyperplasia.
Microscopic
Features:
- Neuroendocrine cells - usually in nests (classic pattern).
- Salt and pepper chromatin - key feature.
- Nuclei round or ellipsoid.
- Size criterion: <5 mm.[3][4]
- Must be through the bronchial basement membrane.[5]
DDx:
- Pulmonary neuroendocrine cell hyperplasia - proliferation confined by bronchial basement membrane.[5]
- Typical carcinoid lung tumour - must be >= 5 mm.
- Pulmonary meningothelial-like nodule - whorled appearance, not associated with an airway.
Images
www:
Sign out
A. Lymph Node, Station 4R, Lymphadenectomy: - Lymph node, NEGATIVE for malignancy. B. Lymph Node, Station 11R, Lymphadenectomy: - Lymph node, NEGATIVE for malignancy. C. Lung, Right Middle Lobe, Lobectomy: - Typical carcinoid tumour (13 mm maximal dimension). - Carcinoid tumourlet (3 mm maximal dimension). - Margins clear of tumour. - Please see tumour summary.
See also
References
- ↑ Bennett, GL.; Chew, FS. (Mar 1994). "Pulmonary carcinoid tumorlets.". AJR Am J Roentgenol 162 (3): 568. PMID 8109497.
- ↑ Ramón Capilla, M.; Arnau Obrer, A.; Navarro Ibáñez, R.; Galbis Caravajal, J.; Traves Zapata, V.; Cantó Armengod, A. (Nov 1996). "[Pulmonary tumorlet. Report of 5 cases].". Arch Bronconeumol 32 (9): 489-91. PMID 9064089.
- ↑ URL: http://pathhsw5m54.ucsf.edu/case7/image75.html. Accessed on: 23 January 2012.
- ↑ He, P.; Gu, X.; Wu, Q.; Lin, Y.; Gu, Y.; He, J. (Dec 2012). "Pulmonary carcinoid tumorlet without underlying lung disease: analysis of its relationship to fibrosis.". J Thorac Dis 4 (6): 655-8. doi:10.3978/j.issn.2072-1439.2012.06.11. PMID 23205296.
- ↑ 5.0 5.1 Koo, CW.; Baliff, JP.; Torigian, DA.; Litzky, LA.; Gefter, WB.; Akers, SR. (Sep 2010). "Spectrum of pulmonary neuroendocrine cell proliferation: diffuse idiopathic pulmonary neuroendocrine cell hyperplasia, tumorlet, and carcinoids.". AJR Am J Roentgenol 195 (3): 661-8. doi:10.2214/AJR.09.3811. PMID 20729444.